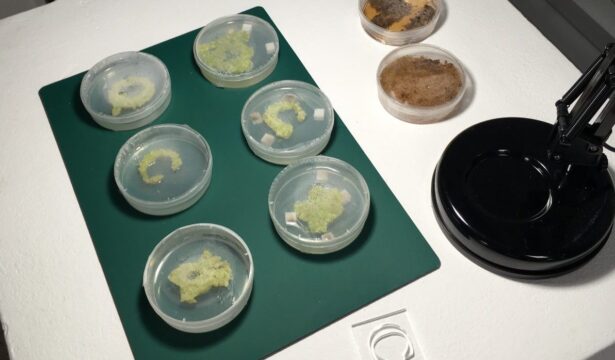
Creating knowledge through collaboration at the interface of art and science

David Harris (PhD)
There has not yet been a good descriptive accounting of the nature and form of existing art and science collaborations although some informal sketches have been outlined and such an accounting has been recommended. This kind of description would be a useful starting point for better understanding how art and science collaboration works in practice, would begin to reveal more about the interacting epistemologies of art and science, would help determine what is meant by successful art and science collaboration, could reveal new potential forms of art and science collaboration, and could lead the way to determining best practice guidelines for future collaborations. Studies of specific, based on existing documentation, will reveal a great deal of information about the concrete aspects of art and science collaborations. They can also provide information about experiences and motivations or participants, although usually through self-report. My creative practice will be used as a testbed for thinking about how scientists and artists might approach a problem, based on my experience in both fields. From there, those projects might become tools with which to explore a variety of forms of collaboration and test hypotheses about how participants might collaborate, make meaning, and form knowledge. This creative practice will also form the basis of techniques to use within an action research methodology to develop productive and effective ways of collaborating.